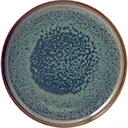

Villeroy & Boch Crafted Crafted Breeze Mattallrik 26 cm har en handgjord skimrande look och är tillverkad i premium porslin. Servera dina maträtter med färg och stil.
275 kr
I lager - Leverans omgående
Beskrivning
Villeroy & Boch Crafted Crafted Breeze Mattallrik 26 cm har en handgjord skimrande look och är tillverkad i premium porslin. Servera dina maträtter med färg och stil.
Specifikation
- Artikelnummer:
- 130283
- Varumärke: Villeroy & Boch
- Serie: Crafted Breeze
- Bredd:
- 25.9 cm
- Längd:
- 25.9 cm
- Höjd:
- 2.7 cm
- Diameter:
- 26 cm
- Vikt:
- 0.88 kg
- Tål diskmaskin:
- Ja
- Tål mikrovågsugn:
- Ja
- Materialspecifikation:
- Premium porslin
- Färg specifikation:
- Blå/grön/brun
- Handdisk rekommenderas:
- Nej
Produktdeklaration
- Tillverkningsland:
- Thailand
Beskrivning
Villeroy & Boch Crafted Crafted Breeze Mattallrik 26 cm har en handgjord skimrande look och är tillverkad i premium porslin. Servera dina maträtter med färg och stil.
Specifikation
- Artikelnummer:
- 130283
- Varumärke: Villeroy & Boch
- Serie: Crafted Breeze
- Bredd:
- 25.9 cm
- Längd:
- 25.9 cm
- Höjd:
- 2.7 cm
- Diameter:
- 26 cm
- Vikt:
- 0.88 kg
- Tål diskmaskin:
- Ja
- Tål mikrovågsugn:
- Ja
- Materialspecifikation:
- Premium porslin
- Färg specifikation:
- Blå/grön/brun
- Handdisk rekommenderas:
- Nej
Produktdeklaration
- Tillverkningsland:
- Thailand